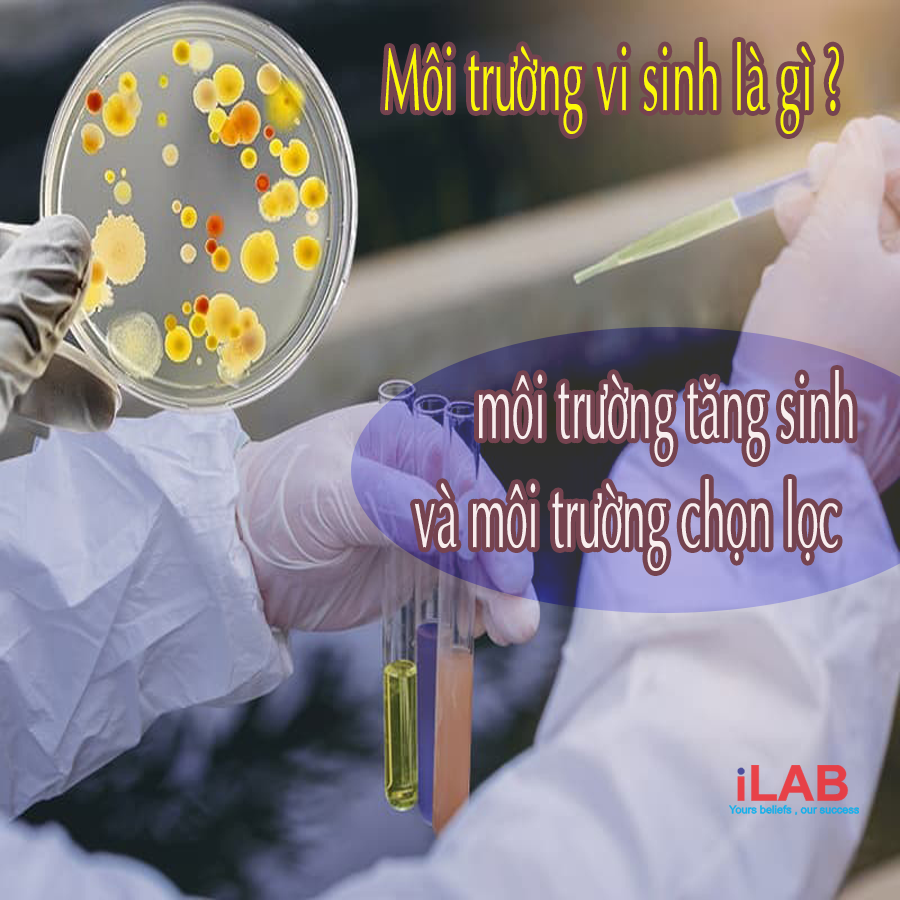
Môi trường vi sinh

Môi trường vi sinh là gì?
Là môi trường nuôi cấy vi khuẩn, là môi trường sinh trưởng được sử dụng để nuôi cấy vi khuẩn. Nó chứa đầy đủ các chất dinh dưỡng cần thiết cho sự phát triển của vi khuẩn, nấm mốc; chúng hoàn toàn có sống bên ngoài chủ thể với môi trường này.
Trên Thế giới, có hàng triệu cuộc xét nghiệm diễn ra mỗi ngày, nó có thể là xét nghiệm máu, nước tiểu, dịch, mô; xét nghiệm bệnh lý trên thủy sản, thực vật… Để xác định xem loại vi khuẩn, nấm mốc nào đang gây hại cho chủ thể thì họ cần phân lập và nuôi nó trên môi trường xác định.
Môi trường vi sinh vật dựa vào mục đích sử dụng
— Môi trường tăng sinh: Môi trường mà ở đó các chất dinh dưỡng như máu, huyết thanh, cao nấm men, mô động vật,… thích hợp với một nhóm vi sinh vật sẽ được bổ sung lên môi trường cơ sở.
Môi trường tăng sinh ( enrich media)
Chúng chứa các chất dinh dưỡng để hỗ trợ sự phát triển của nhiều loại vi sinh vật. Môi trường tăng sinh cung cấp cả tác nhân hóa học và vật lý để tăng số lượng vi sinh vật. Không có tác nhân ức chế nào được sử dụng để ngăn chặn sự phát triển của các vi sinh vật không mong muốn. Môi trường tăng sinh như enriched broth, selenite broth, và Gram-negative broth. Sau khi tăng sinh xong, các vi sinh vật cần thiết có thể được phân lập bằng kỹ thuật nuôi cấy khác.
— Môi trường nuôi cấy chọn lọc: Đây là loại môi trường được sử dụng cho từng nhóm vi sinh vật riêng biệt. Có nhiều trường hợp môi trường chọn lọc được thiết kế dựa trên nhu cầu dinh dưỡng đặc biệt của từng nhóm vi sinh vật nhất định. Ví dụ: Môi trường Eosin Methyene Blue để phát hiện vi khuẩn Gram dương như Coliform, môi trường vô đạm Ashby dùng để phân lập vi khuẩn Acrobat.
Môi trường chọn lọc (Selective media)
Chúng cho phép một số loại vi sinh vật phát triển do không có một số chất dinh dưỡng quan trọng khiến nó không thuận lợi cho hầu hết các vi sinh vật, các chất ức chế trong môi trường ngăn chặn sự phát triển của các vi sinh vật không mong muốn và cung cấp các chất hỗ trợ phân lập và nhận dạng nhanh chóng cho vi sinh vật bằng cách ức chế sự phát triển không mong muốn. Chất ức chế được thêm vào môi trường có thể là muối, axit, thuốc nhuộm, kháng sinh (ví dụ, streptomycin, kanamycin, chloramphenicol và gentamicin) và những chất khác. Ví dụ như môi trường PDA nuôi được nấm vì nó có pH thấp 5,6 và nồng độ glucose cao.
Crystal violet hoặc brilliant green dye được thêm vào để ức chế sự phát triển của vi khuẩn Gram dương mà không ảnh hưởng đến sự phát triển của vi khuẩn Gram âm. Mặt khác, thạch phenylethanol ức chế sự phát triển của vi khuẩn Gram âm, nhưng không ức chế được vi khuẩn Gram dương.
Các chất kháng sinh được thêm vào một số môi trường để làm cho chúng có tính chọn lọc đối với các vi sinh vật kháng lại các chất kháng khuẩn này, chẳng hạn như Salmonella-Shigella agar và CIN agar.

MÔI TRƯỜNG VI SINH CÔNG TY ILAB CUNG CẤP
| Môi trường vi sinh Hicrome Vibrio Agar – M1682 – Himedia |
| Môi trường vi sinh EC Broth – M127 – Himedia |
| Môi trường vi sinh Plate count agar – M091 – Himedia |
| Môi trường vi sinh Lactose sulphite broth – M1287 – Himedia |
| Môi trường vi sinh Agar agar – GRM666 – Himedia |
| Môi trường vi sinh DRBC agar – M1881 – Himedia |
| Môi trường vi sinh MTCVS Potato dextrose agar – M096 – Himedia |
| Môi trường vi sinh Tryptone Broth – M463 – Himedia |
| Môi trường vi sinh Hicrome Candida Differential Agar – M1297A |
| Môi trường vi sinh Hektoen Enteric Agar – M467 – Himedia |
| Môi trường vi sinh Hichrome Chromogenic Coliform Agar (CCA) – M1991I |
| Môi trường vi sinh Green brilliant bile broth 2% – M121 |
| Môi trường vi sinh Baird parker agar – M043 |
| Môi trường vi sinh EMB agar – M317 |
| Môi trường vi sinh Violet Red Bile Glucose Agar – M581 |
| Môi trường vi sinh Buffered glucose Broth – M070 |
| Môi trường vi sinh Lactosebacillus MRS Broth – M369 |
| Môi trường vi sinh TBX Trypyone Bile X-Glucuronide agar – 1161220500 – Merck |
Và còn nhiều chất khác nữa ….